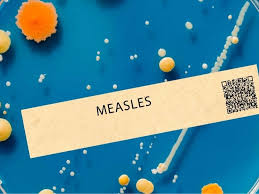

Wayne, NJ flagged as moderate risk for measles outbreak
Locales: New Jersey, UNITED STATES
Wayne, NJ - February 1st, 2026 - A new report released today by Yale University's School of Public Health paints a concerning picture of measles vulnerability across the United States, and Wayne Township is flagged as being at moderate risk for an outbreak. The report, which utilizes a sophisticated modeling system, identifies counties susceptible to resurgences of this highly contagious and potentially deadly disease. The findings underscore the critical importance of vaccination and proactive public health measures.
The Yale model isn't simply a blanket assessment; it's a complex analysis incorporating vital factors such as vaccination coverage rates, population density, and international travel patterns. These elements are interwoven to predict the likelihood of measles introduction and subsequent spread within individual counties. Wayne's moderate risk designation signals that while an outbreak isn't imminent, conditions are present that could quickly allow the virus to gain traction.
Understanding the Measles Threat
Measles, a highly contagious viral infection, remains a significant public health concern despite the availability of a safe and effective vaccine. The virus spreads through respiratory droplets produced when an infected person coughs or sneezes, making crowded environments particularly vulnerable. Symptoms typically begin with a high fever, persistent cough, runny nose, and conjunctivitis (red, watery eyes). A characteristic red, blotchy rash then emerges, typically starting on the face and spreading throughout the body.
However, the disease is far more dangerous than just these unpleasant symptoms. Measles can lead to severe complications, especially in young children and individuals with weakened immune systems. These complications include pneumonia, encephalitis (inflammation of the brain, potentially leading to permanent neurological damage), otitis media (ear infections), and, tragically, even death. Prior to widespread vaccination, measles was a leading cause of childhood mortality.
Wayne's Vulnerability: A Deep Dive
The Yale report specifically points to declining vaccination rates as the primary driver of Wayne's increased risk. While historically, the measles vaccine (MMR - measles, mumps, and rubella) has been highly effective in controlling the disease, several factors are contributing to waning immunity and a resurgence of hesitancy. These include misinformation campaigns spreading online, logistical barriers to accessing healthcare, and a general erosion of trust in public health institutions in some segments of the population.
"We are seeing a troubling trend of declining MMR vaccination rates nationally, and Wayne is unfortunately reflecting that," explains Dr. Eleanor Vance, lead researcher on the Yale report. "Even a small drop in vaccination coverage can significantly increase the risk of outbreaks, particularly in densely populated areas like Wayne. Travel plays a role as well; individuals who are unvaccinated and travel internationally can bring the virus back with them, potentially seeding an outbreak within the community."
Experts emphasize that two doses of the MMR vaccine are generally considered sufficient for lifelong immunity, however, immunity isn't always absolute, and boosters may be recommended in certain circumstances. The report also highlights that waning immunity over time means that individuals vaccinated decades ago might be susceptible, contributing to the overall risk.
What Can Wayne Residents Do?
Public health officials are urging Wayne residents to take immediate action to protect themselves and their families. The New Jersey Department of Health strongly recommends that all individuals, especially children, are up-to-date on their MMR vaccinations.
"Vaccination isn't just about protecting yourself; it's about protecting the entire community," stated a spokesperson for the department. "When enough people are vaccinated, it creates 'herd immunity,' which helps to shield those who are unable to be vaccinated, such as infants too young to receive the vaccine or individuals with certain medical conditions."
Residents are encouraged to check their vaccination records or contact their healthcare provider to ensure they and their children are fully protected. The full Yale report, including an interactive map illustrating measles risk across the country, can be found here: [ https://environment.yale.edu/news/measles-risk-map/ ].
Patch has reached out to the Wayne Health Department for comment and will update this article with their response as soon as it is received. Residents are also encouraged to check the Wayne Township official website for local health advisories and vaccination clinics. The potential for a measles outbreak is a serious concern, but proactive vaccination and community awareness can significantly mitigate the risk and safeguard the health of Wayne residents.
Read the Full Patch Article at:
[ https://patch.com/new-jersey/wayne/measles-risk-wayne-see-outbreak-likelihood-map-new-report ]